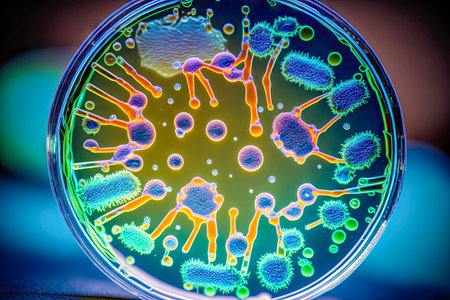
macro close up of bacteria cells.の素材

素材 - macro close up of bacteria cells.
キーワード
- 3d
- abstract
- atom
- background
- bacteria
- bacterium
- biology
- blood
- blue
- cancer
- cell
- dangerous
- digitally
- disease
- flowing
- flu
- genetic
- genetics
- germ
- green
- health
- human
- hygiene
- ill
- illness
- illustration
- infection
- life
- macro
- magnification
- many
- medical
- medicine
- membrane
- micro
- microbe
- microbiology
- microscopic
- molecular
- molecule
- molecules
- nucleus
- organism
- research
- science
- scientific
- sick
- sickness
- tiny
- virus
類似作品
Close-up of bac...
Surface contami...
Macro close up ...
Dynamic motion ...
Threads of fung...
Close-up of ger...
Colorful bacter...
Bacteria and vi...
Surface with ba...
Conceptual imag...
Visualization o...
Blue bacteria w...
High-res image ...
Diverse colorfu...
A close-up of b...
Bacteria on a s...
Close-up of ger...
Microscopic Vie...
Microbes are se...
A detailed digi...
Scientific imag...
Gene Mutations,...
Microscopic bac...
A close up of a...
Bacteria macro ...
Escherichia col...
Helicobacter py...
Diverse colorfu...
High-definition...
cyan colored ba...
Pills encircle ...
Green bacteria ...
3d illustration...
Digital illustr...
Cells that caus...
Vibrant 3D rend...
bacterium rod m...
Bacteria cells ...
Microscopic Vie...
Diverse colorfu...
close-up of bac...